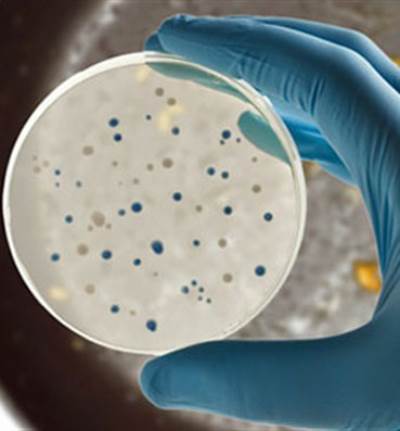
كيف تتخلصين من 10 ملايين بكتيريا في مطبخك؟

لوبولو .. رائحة المطبخ البرتغالي في نيويورك

لو لم يكن جورج مينديز متمتعًا بقدرة كبيرة على إحكام قبضته على النكهات والنباتات العطرية البرتغالية، ربما كان «لوبولو» سيخرج عن نطاق سيطرته. قد يكون هذا المطعم مثيرًا للحيرة بداية الأمر، حيث يبعث برسائل مختلطة، وتتوه رسالته البسيطة أحيانًا تحت وطأة تعقيدات كثيرة.
ومع ذلك، فإنه عند منح هذا المكان فرصة، يمكنك أن تجد وضوحًا في روائح الثوم والخشب التي تملأ قاعة تناول الطعام، بجانب تصاعد روائح الفلفل الأحمر والكزبرة المقلية في زيت الزيتون، والمأكولات البحرية الطازجة والسردين المشوي، والتي يغطيها صوص غني وكثيف. ورغم أن المظهر العام للمطعم ربما يوحي بغياب التركيز، فإن هذا الأمر لا ينطبق مطلقًا على الطهي بداخله.
وقد اتسمت فكرة مينديز الرئيسة بخصوص «لوبولو» Lupulo، الذي افتتح أبوابه على بعد بضعة بنايات جنوب هيرالد سكوير في أبريل (نيسان)، بالمباشرة والوضوح.
يعني اسم المطعم «القفزات»، ويشبه المقاهي الأميركية، خاصة بالنظر إلى مقاعده الخشبية الخشنة وأسقفه العالية وطاولة الطعام التي تتخذ شكل U وتمتد لمسافة طويلة. ويتميز لحم الدجاج المشوي بطعم ممتع وقوام طري حتى العظم.
ويجري تقديم الدجاج المشوي مع بططا مقلية على الطريقة الفرنسية وزجاجة من الصوص الحار المصنوعة من فلفل «بيري بيري»، ما يوحي بأن لدى آباء الشعب البرتغالي فكرة متقدمة عما يمكن وصفه بلذة الألم.
كما يجري طهو محار «مانيلا» مع كزبرة وقطع من الثوم، وهو طبق بسيط ورائع، خاصة لدى تناوله مع خبز محمص تم وضعه بعض الوقت في مرق المحار.
أما طبق محار «كاراكويس» الذي يقدمه «لوبولو» فعبارة عن قواقع بوروغوندي المكشوفة من دون صدف داخل طبق، وليس النوع الآخر الأصغر الذي اعتاد الناس على مصه من داخل الصدف واحدة تلو الأخرى في مساء أيام الصيف بلشبونة.
من المنظور التجاري البحت، يتعين على مينديز شحن هذه الأطباق إلى مطعم «ألديا»، لكنني أتمنى ألا يفعل ذلك، لأن إبداعاته هناك لا تقل روعة عن أطباقه المتميزة في «لوبولو»، مثل سمك النهاش غير المطهو مع فلفل «سيرانو» الحارق والذي يجري التخفيف من ألمه بإضافة بعض من مرق جوز الهند ويحمل عبق ليمون «ماركوت» - وهو طبق يتميز بروح برتغالية.
أما قائمة الطعام الخاصة بـ «لوبولو» فتثير حالة من الارتباك، ذلك أنها مقسمة إلى أطباق صغيرة وأسماك ولحوم، رغم أنه في حقيقة الأمر ستكتشف أن جميع الأطباق صغيرة فيما عدا الأطباق الأربعة الأخيرة من السمك.
إلا أن هذا يهون مقارنة بصعوبة الجلوس في قاعة الطعام، ذلك أن الجدران التقليدية المغطاة بقرميد خزفي برتغالي وتحمل اللونين الأزرق والأبيض، علاوة على نافذتين بالغتي الضخامة وقدر كبير من التجهيزات المصنوعة من الخشب، تجعل من الصعب تبادل الحديث داخل القاعة بحلول الثامنة مساء واكتظاظ القاعة. وربما لا تمثل القاعة مشكلة حال إدخال تعديلات سمعية عليها.
العنوان: 835 سيكس أفنيو (29 ستريت) تشيلسي 7600 - 290 - 212 lupulonyc.com